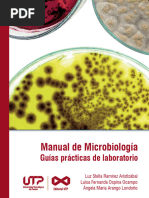

0% encontró este documento útil (0 votos)
216 vistas8 páginasTipos de Hipótesis Científicas
Este documento describe los diferentes tipos de hipótesis de investigación científica. Explica que existen cuatro tipos principales: la hipótesis nula, las hipótesis generales o teóricas, las hipótesis de trabajo y las hipótesis alternativas. Dentro de las hipótesis de trabajo, se especifican tres subtipos: las hipótesis atributivas, asociativas y causales. Además, señala que una hipótesis es una declaración tentativa sobre una posible relación entre variables que puede ser probada
Cargado por
fatimaDerechos de autor
© © All Rights Reserved
Nos tomamos en serio los derechos de los contenidos. Si sospechas que se trata de tu contenido, reclámalo aquí.
Formatos disponibles
Descarga como DOCX, PDF, TXT o lee en línea desde Scribd
0% encontró este documento útil (0 votos)
216 vistas8 páginasTipos de Hipótesis Científicas
Este documento describe los diferentes tipos de hipótesis de investigación científica. Explica que existen cuatro tipos principales: la hipótesis nula, las hipótesis generales o teóricas, las hipótesis de trabajo y las hipótesis alternativas. Dentro de las hipótesis de trabajo, se especifican tres subtipos: las hipótesis atributivas, asociativas y causales. Además, señala que una hipótesis es una declaración tentativa sobre una posible relación entre variables que puede ser probada
Cargado por
fatimaDerechos de autor
© © All Rights Reserved
Nos tomamos en serio los derechos de los contenidos. Si sospechas que se trata de tu contenido, reclámalo aquí.
Formatos disponibles
Descarga como DOCX, PDF, TXT o lee en línea desde Scribd